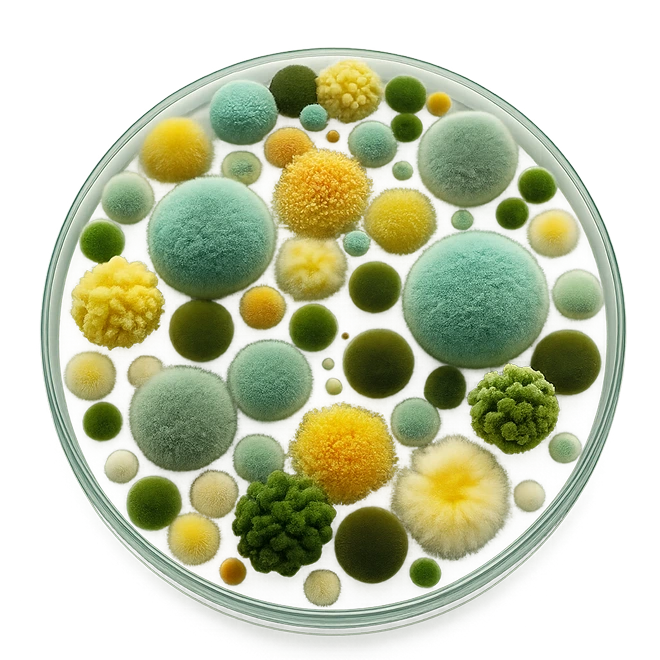

OUR COMMITMENT TO CLEAN TESTING
We test so you don’t have to wonder.
WHAT WE TEST FOR AND WHY IT MATTERS
Every batch is screened for key microbiological contaminants that can impact your dog’s health.
These tests help ensure our products are free from harmful bacteria and safe for daily use — especially for dogs with sensitivities.
01. Yeast and mold
High yeast and mold counts can lead to digestive upset, skin issues, and allergic reactions — especially in dogs with existing sensitivities. Mold can also produce mycotoxins, which are harmful compounds that affect the liver, immune system, and overall health.
Our Standard:

02. Staphylococcus aureus
Staph is a common bacteria that can cause skin infections, abscesses, and inflammation. If ingested, it can lead to vomiting, diarrhea, and in rare cases, more serious systemic infections. Dogs with allergies or compromised immune systems are especially at risk.
Our Standard

03. E. Coli
E. coli contamination is a sign of poor hygiene during manufacturing. It can cause severe gastrointestinal illness in dogs — symptoms include vomiting, diarrhea, fever, and lethargy. Some strains are more dangerous than others and can be life-threatening.
Our Standard:

04. Salmonella SPP.
Salmonella poses a dual risk: it can make your dog sick, and it can also spread to humans through handling contaminated products. In dogs, it causes vomiting, diarrhea (sometimes bloody), dehydration, and fever. In vulnerable pets, it can become systemic.
Our Standard:
Our Testing Process
All tests are performed using validated AOAC Internationa methods, recognized as the scientific standard for food and supplement safety. Testing is conducted by a third-party laboratory unaffiliated with our brand, ensuring objectivity and accuracy.

Why This Is Important to Us
Supplements are only as good as their safety — especially when they’re part of your dog’s daily routine. Many pet products skip this step, but we believe third-party testing is a non-negotiable.



